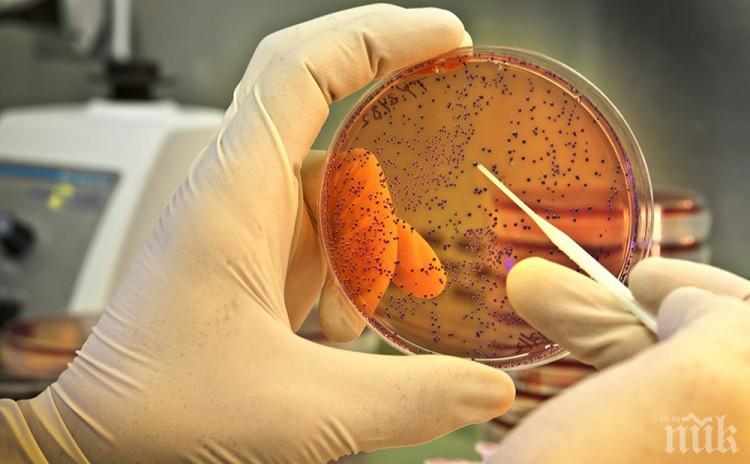
Дете почина от Ешерихия коли

ПИК с нов канал в Телеграм
Последвайте ни в Google News Showcase
2-годишно момченце е починало миналата седмица в Сан Диего, след като се е заразило с Ешерихия коли, докато е било с родителите на фермерски пазар в града.
От здравните власти в щата Калифорния потвърдиха за смъртния случай, допълвайки, че още три деца на възраст между 2 и 16 години са били приети в болница с Ешерихия коли, но малко след това са били изписани и няма опасност за живота им.
,,Четири деца бяха хоспитализирани, като три бяха освободени за домашно лечение, но за жалост четвъртото - 2-годишно момченце, почина след усложнения'', обясниха в прессъобщение до медиите здравните органи.
Заради инцидента фермерският пазар е затворен, а всички животни са били откарани за лабораторни анализи, информираха още световните агенции.
Бактерията Ешерихия коли има стотици разновидности, повечето от които са безвредни, но има определени щамове, които при усложнения могат да доведат до трагичен край.